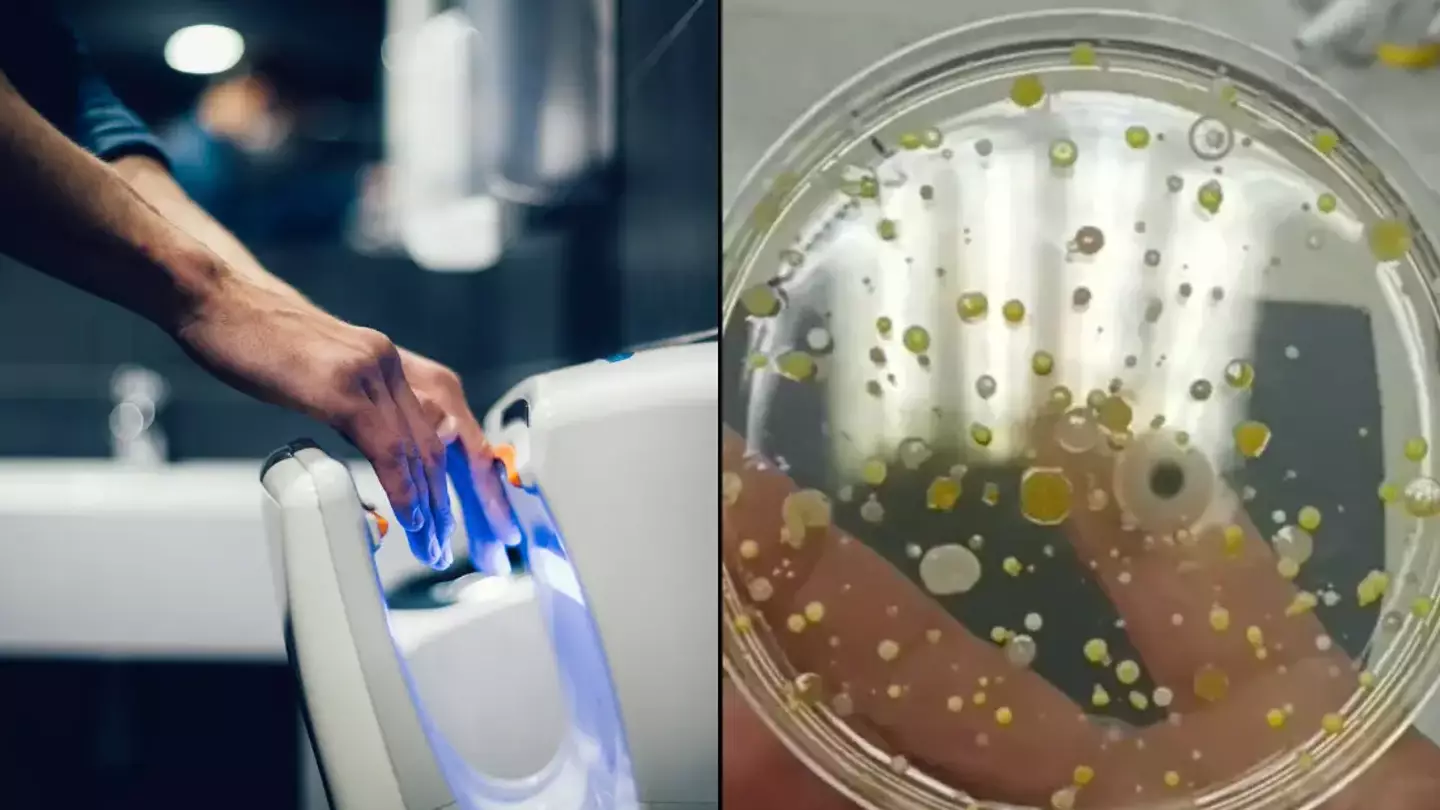

A scientist has carried out a gross yet important experiment to do with public hand dryers.
You've probably heard stories and warnings about them not being the cleanest - though what choice do we have nowadays?
The majority of public toilets in the UK have taken away the option of paper towels to dry your hands after washing them, for the environment's sake - and rightly so.
But what does this leave us with? Something gross, unfortunately.
Advert

Hand dryers are all we've been left with, and scientist Ruth - known as Devon Science on TikTok - has revealed exactly how unsanitary they can be.
In a video that has gone viral, accumulating over 4.7 million views, the expert simply placed a petri dish under a dryer as it blew air out, collecting whatever was produced.
She then collected air from her lab and left both of the dishes overnight before discovering the results the next day.
The results were harrowing, as the petri dish with hand dryer showed that different types of bacteria and fungus had grown across the plate, forming disgusting yellow-looking spots, with some black and white smudges too.
Advert
But the dish that was waved through the air, which was meant to signify someone waving their hands dry, stayed totally clear.
It may take longer, but for hygiene purposes, it looks like this is by far the best way to do things.
But how about toilet paper? It is another option, after all.
In another video, Ruth rubbed a petri dish on the toilet paper and this too grew bacteria, albeit a lot less than what was on the hand dryer dish.
So, where is all that bacteria coming from if not the toilet air?
Advert

Well, last but not least, to further highlight her point, the scientist swabbed the inside of the dryer, which made the cotton bud black, and put that on a petri dish.
This grew several types of bacteria, which looked strikingly similar to what was being blown out.
So, to conclude, Ruth stated: "Now I know where the bacteria are coming from, they are actually living inside the machine."
The specific type of bacteria wasn't specified, but does it really matter?
Advert
Users took to the comments to share what they thought of the results, as one pointed out: "What scares me is I work for the NHS and they took away our hand towels and we are forced to use the hand dryers..even removed the bins so couldn't use the loo roll to dry!"
Another said: "I stopped using hand dryers after seeing these videos."
A third added: "Neeeeever use hand dryers," and they're right.
Just fling your hands dry, lads!